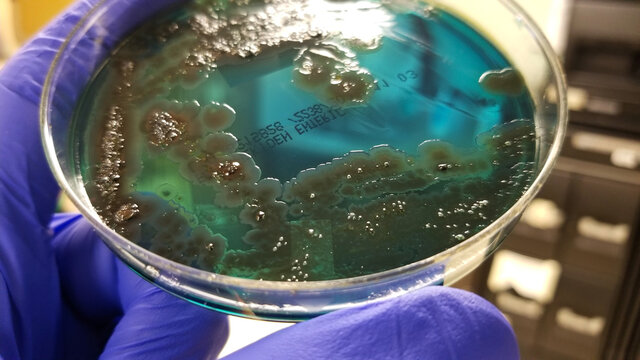
PseudomonasBilder StockFotos & Videos. Adobe Stock

Pseudolmedia es un género con 34 especies de plantas de flores de la familia Moraceae.[1]
Especies seleccionadas
- Pseudolmedia alnifolia
- Pseudolmedia brosimifolia
- Pseudolmedia bucidaefolia
- Pseudolmedia coriacea
- Pseudolmedia eggersii
- Pseudolmedia ferruginea
- Pseudolmedia gentryi
- Pseudolmedia glabrata
- Pseudolmedia guaranitica
- Pseudolmedia havanensis
- Pseudolmedia hirsuta
- Pseudolmedia oxyphyllaria
- Pseudolmedia spuria (Sw.) Griseb. - macagua amarilla de Cuba[2]
Sinónimos
- Olmedia Ruiz & Pav.
- Olmediopsis H. Karst.
Referencias